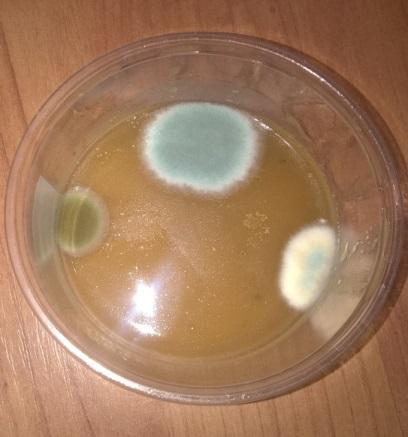
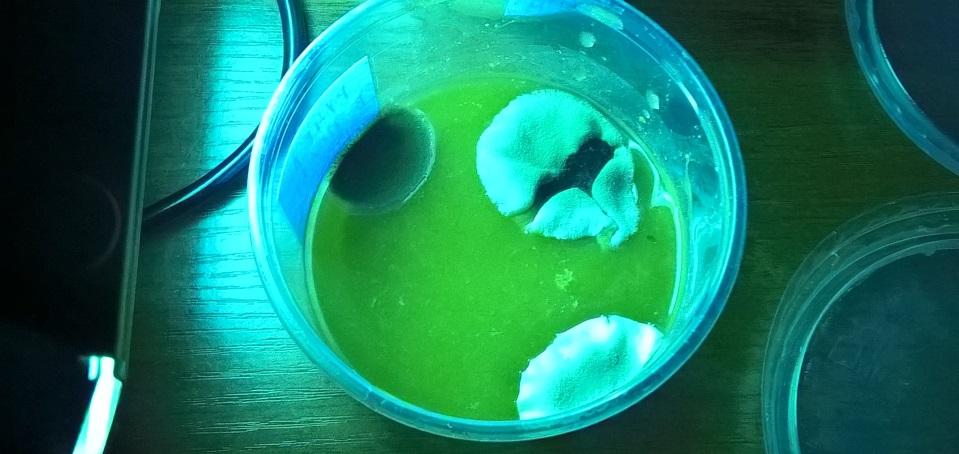
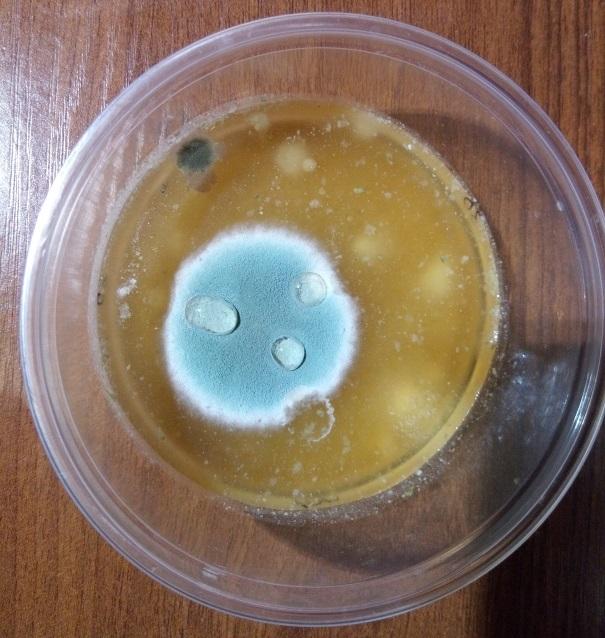
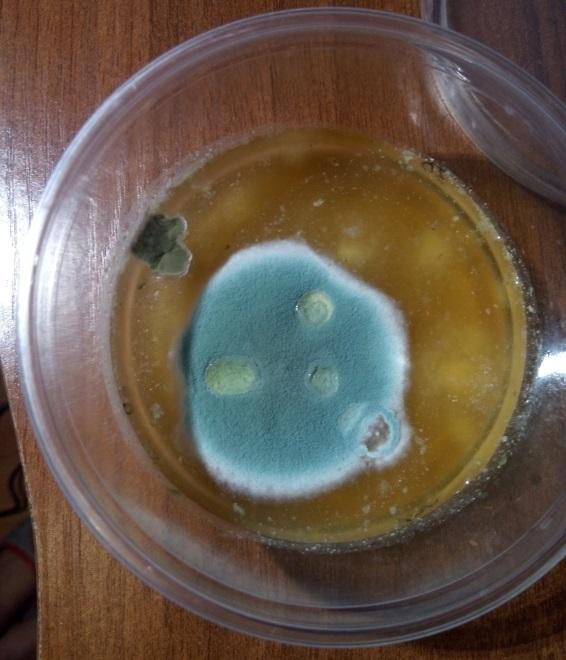
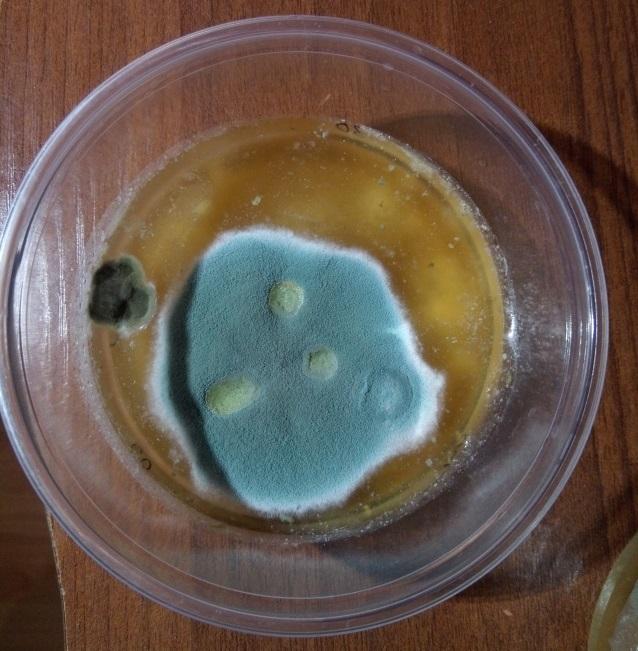

Оглавление
| Введение
| стр.2 |
| Глава 1. Бактерии и методы их уничтожения
| стр.3 |
| 1.1 Бактерии и их свойства
| стр.3 |
| 1.2 Классификация бактерий
| стр.4 |
| 1.3 Методы борьбы с бактериями
| стр.6 |
| Глава 2. Исследовательская работа по уничтожению бактерий
| стр.13 |
| 2.1 Выращивание колоний бактерий
| стр.13 |
| 2.2 Опыт с антибактериальным средством
2.3 Опыт с ультрафиолетовой лампой
2.4 Опыты с антибиотиками | стр.15
стр.16
стр.17 |
|
Заключение
|
стр.21 |
| Список литературы | стр.22 |
Введение
Бактерии являются самыми древними живыми организмами на земле, и появились они около 3 миллиардов лет назад, но изучать их стали только 3 столетия назад. Бактерии – это микроорганизмы, живущие в своем громадном невидимом мире как снаружи, так и внутри нас. Они населяют все, что нас окружает - человеческое тело, воздух, поверхности, пищу, растения. На Земле нет такого места, где невозможно найти эти крошечные живые организмы.
В современном мире проблема борьбы с болезнетворными бактериями стоит очень остро, ведь они являются причиной серьезных заболеваний. Существует много различных методов борьбы с ними, но не все они эффективны.
Цель моего исследования – изучить различные методы борьбы с бактериями и выяснить, какие из них наиболее действенные.
Для достижения поставленной цели необходимо решить следующие задачи:
- выяснить, какие бывают виды бактерий;
- выявить благоприятные и неблагоприятные условия для их размножения;
- узнать, какие бывают способы борьбы с бактериями.
- провести исследования и узнать, какие из способов являются наиболее эффективными.
Гипотеза – современные средства борьбы с бактериями способны защитить нас от их пагубного воздействия.
Глава 1. Бактерии и методы их уничтожения
1.1 Бактерии и их свойства
Бактерии - древнейшие живые организмы на Земле. Их можно найти в любой среде обитания и в любой точке земного шара. Больше всего их обитает в почве, но также они водятся и в воздухе, воде, пищевых продуктах, внутри и снаружи любых живых существ. Бактерии даже были обнаружены в таких местах, где другие организмы просто не могут выжить, например, в вулканах, ледниках, глубинах океана, высоко в атмосфере, сверхсоленых водоемах, недрах земли.
Чаще всего, бактерия - это одна клетка, но встречаются и колониальные формы. Причем эта клетка совсем крошечная – всего несколько десятков микрометров. Но главной особенностью бактериальной клетки является отсутствие клеточного ядра, они принадлежат к классу прокариот.
Бактерии появились в самом начале зарождения жизни на Земле, и именно им принадлежит открытие различных способов питания. Питание - это метод получения клеткой или организмом необходимых органических веществ. Получить их можно от внешних источников или синтезировать самостоятельно из неорганических веществ. Бактерии питаются и тем, и другим способом. Бактерии, которые получают питание, синтезируя органические вещества из неорганических, нуждаются в энергии, ее они получают либо от солнца, либо от различных химических реакций. Другие бактерии, не способные синтезировать, получают питание из окружающей среды, например, остатки других организмов, мертвые тела.
Размножаются бактерии путем деления их клетки надвое. В благоприятных условиях окружающей среды и при достаточном количестве питательных веществ клетки делятся довольно быстро. За сутки количество бактерий может достигнуть сотни миллионов.
Большая часть бактерий в неблагоприятных условиях формируют споры. Споры бактерий — это такой метод переживания неблагоприятных условий и метод расселения. В процессе образования споры цитоплазма клетки бактерии стягивается, а сама клетка обрастает тугой толстой защитной оболочкой. Споры бактерий способны сохранять жизнеспособность в течение долгого времени и переносить экстремально высокие и низкие температуры, высыхание. Когда спора снова оказывается в благоприятных условиях, то она набухает и ее защитная оболочка скидывается, и появляется обычная бактериальная клетка. Случается так, что при этом осуществляется деление клетки, и появляется несколько бактерий. В таком случае спорообразование сопровождается размножением.
1.2 Классификация бактерий
Формы бактерий
По своей форме бактерии бывают: круглые, палочковидные и извилистые.
Некоторые бактерии сливаются в колонии, поэтому из также различают по типу соединений:
• Диплококки – кокки, соединенные парами.
• Стрептококки – кокки, образующие цепочки.
• Стафилококки – кокки, образующие гроздья.
• Стрептобактерии – палочковидные микроорганизмы, соединенные в цепочку.
Свойством бактерий палочковидной формы является их способность к спорообразованию. Такие бактерии называют бациллами, и к ним относят:
• Род клостридиум (вызывают газовую гангрену, ботулизм).
• Род бациллюс (вызывают сибирскую язву, ряд пищевых отравлений).
Споры бактерий – это законсервированная клетка микроорганизма, которая может продолжительное время оставаться без повреждений, подвергаясь внешним влияниям. Например, споры термоустойчивы, не повреждаются под влиянием химикатов. Единственное возможное воздействие – это ультрафиолетовые лучи, под которыми высушенные бактерии могут погибнуть.
Споры бактерий образовываются тогда, когда сами бактерии попадают в неблагоприятные условия. Спора внутри клетки формируется 18-20 часов. За это время бактерия теряет воду, уменьшается, становится легче, а под внешней мембраной образуется плотная оболочка. В таком виде микроорганизм способен замереть на несколько сотен лет.
Когда спора оказывается в подходящих условиях, она превращается в жизнеспособную бактерию.
Виды бактерий
По влиянию бактерии делятся на патогенные, условно-патогенные, непатогенные.
Непатогенные бактерии – это микроорганизмы, которые не вызывают болезни, даже при их большой численности. Наиболее известные молочнокислые бактерии, их активно используют в пищевом производстве – для приготовления сыров, кисломолочных продуктов, теста и других продуктов питания.
Еще один вид – бифидобактерии, которые составляют основу кишечной микрофлоры. Они защищают кишечник от проникновения патогенных организмов; вырабатывают органические кислоты, препятствующие размножению микробов; помогают синтезировать витамины (К, группа В) и белки; усиливают усвоение витамина D.
Роль бифидобактерий неоценима, без них невозможно нормальное пищеварение и усвоение питательных веществ.
Условно-патогенные бактерии
Эти бактерии годами существуют на коже, в носоглотке и кишечнике человека и не вызывают болезней, но при любых благоприятных условиях (ослабление иммунитета, нарушения микрофлоры) их число растет, и они становятся настоящей угрозой.
Примерами условно-патогенных бактерий являются золотистый стафилококк, стрептококки, кишечная палочка, хеликобактер пилори.
Избавляться от них нет смысла, т.к. они распространены в окружающей среде. Единственным методом профилактики является укрепление иммунитета.
Наличие в организме патогенных бактерий всегда ведет к развитию инфекции. Даже маленькая колония может причинить вред. Большинство бактерий выделяют токсины: эндотоксины – яды, образующиеся при разрушении клетки и экзотоксины – яды, которые бактерия вырабатывает в процессе жизнедеятельности.
Лечение обычно направлено на уничтожение болезнетворных бактерий и на снятие отравления, которые они вызвали. Наиболее известные бактерии: сальмонелла, синегнойная палочка, гонококк, бледная трепонема, шигелла, туберкулезная палочка (палочка Коха).
1.3 Методы борьбы с бактериями
Предупредить пищевые продукты от порчи можно, главным образом, двумя способами. Первый – это стерилизация, когда продукт нагревают, чтобы уничтожить все микроорганизмы, а для того, чтобы предотвратить дальнейшее загрязнение, его помещают в герметичную тару. Второй способ заключается в сохранении продукта методом замедления развития бактерий, являющихся возбудителями порчи. Это достигается различными обработками пищевого продукта, в результате чего деятельность бактерий притормаживается. При таком способе бактерии не всегда уничтожаются, а при снижении воздействия, замедляющего их развитие, пищевой продукт начинает портиться.
В промышленном производстве используются в основном такие методы: замораживание, газовое хранение, сушка (обезвоживание), фильтрование, маринование, квашение, копчение, облучение и внесение естественных консервантов, таких как сахар, соль, кислоты, пряности и химические консерванты.
Замораживание
При низкой температуре продукты остаются свежими из-за торможения или прекращения роста бактерий - возбудителей порчи. В самом начале замораживания количество жизнеспособных микроорганизмов стремительно снижается. В зависимости от видов бактерий, температуры и других факторов число выживших микроорганизмов может затем постепенно медленно снижаться.
По мнению ученых, есть несколько причин вымирания бактерий после воздействия холодом: во-первых, прямое воздействие холодом вызывает гибель бактерий, во-вторых, кристаллы льда механически повреждают клетки бактерий, в-третьих, изменяются белки, содержащиеся в клетках бактерий.
Существуют микроорганизмы, которые устойчивы к воздействию низких температур. Некоторые типы бактерий, плесени и дрожжей выжили в замороженной землянике 3 года. Точно установлено, что при быстрой заморозке земляники при температуре -18°, бактерии Eberthella lyphosa выживают 6 месяцев, Staphylococcus aureus - 5 месяцев и бактерии типа Salmonella - 1 месяц.
Газовое хранение
Заметного уменьшения количества бактерий, вызывающих порчу продуктов, можно добиться изменением состава воздуха помещения, где хранятся продукты. При хранении в холодильнике сырых продуктов питания введение углекислоты, озона, сернистого ангидрида или треххлористого азота в атмосферу хранилища приостанавливает рост бактерий, увеличивая срок хранений пищевых продуктов. 40% концентрация углекислоты полностью тормозит рост бактерий на мясе, но это сказывается на качестве мяса, оно теряет цвет. На практике обычно используют 10% концентрацию углекислоты, так охлажденное мясо не портится в течение 60-70 дней, но при этом сохраняет цвет.
Углекислый газ и холодильное хранение успешно практикуется для предотвращения порчи плодов, например, яблок и груш. Используемая концентрация зависит от вида сорта плодов; но чаще требуются достаточно высокие концентрации углекислого газа.
Озонирование особенно эффективно при хранении яиц. Если обеспечить достаточную влажность помещения, то срок хранения можно увеличить до 8 месяцев. Озон также эффективен при хранении сырых плодов ягод, но он не предотвращает загнивания цитрусовых плодов.
Снижение влаги в продукте
Для снижения влаги можно использовать обезвоживание, т.е. сушку, сублимацию и вяление. Эти способы уменьшают количество влаги до величины, при которой рост бактерий прекращается. Развитие бактерий происходит при доле влаги в продукте 25-30% и больше. При снижении влаги в продукте бактерии отдают свою влагу осмотическим путем, т.е. через поверхность своего тела, в результате чего происходит распад их клеток, и они прекращают свою деятельность. Однако есть бактерии, которые во время сушки впадают в анабиоз и остаются жизнеспособными.
Недостатками этого метода являются изменение вкусовых качеств продукта и потеря полезных веществ.
Применение соли
Соль используют для подавления жизнеспособности бактерий из-за повышения осмотического давления в продукте. Высокое давление обезвоживает и разрушает клетки бактерии, вытягивая из них воду. Кроме того, при солении овощей происходит выделение молочнокислых бактерий с образованием молочной кислоты, которая имеет консервирующее свойства. Она подавляет рост патогенных бактерий.
Применение кислот
Кислоты обладают токсичностью в отношении бактерий. Для пищевых продуктов чаще всего используют уксусную и молочную кислоты. Исследования показывают, что уксусная кислота более токсична, чем молочная кислота. При подкислении уксусной кислотой рост бактерий прекращается при уровне кислотности pH 4,9. В нетоксической концентрации уксусная кислота наоборот стимулирует рост микроорганизмов, являясь источником энергии.
Химические консерванты
Под термином «консервант» понимается любое вещество, которое препятствует, замедляет или прекращает процессы порчи и гниения пищевых продуктов. Сюда не входят соль, селитра, сахар, молочная и уксусная кислоты, глицерин, спирт, пряности, эфирные масла и душистые травы. Химические вещества имеют свойство консервации, они оказывают токсическое действие на клетку. Но действие химических консервантов не ограничивается только клетками бактерий, они обычно вредны и для тканей тела. Поэтому использование их в пищевых продуктах ограничено законодательством. Разрешенные консерванты: сернистый ангидрид (включая сульфиты), бензойная кислота (включая ее соли) и дифенил.
Презервирование со специями (пряностями)
Некоторые специи и пряности обладают консервирующим свойством, кроме того, эфирные масла некоторых специй более эффективны, чем химические консерванты. Например, гвоздика, корица и горчица обладают наиболее высоким консервирующим действием. Исследования показали что, разные микроорганизмы по-своему реагируют на действие специй. Считается, что токсичные свойства эфирных масел специй развиваются за счет химических, а не физических факторов.
Антибиотики
Бактерии в природе можно найти везде. Как и любые другие живые существа, они ведут между собой борьбу за существование. Их основным оружием являются особые вещества, которые вырабатываются одними видами бактерий и пагубно действуют на другие виды. Такие вещества называются антибиотиками.
Первый антибиотик – пенициллин - был случайно обнаружен, когда в 1920-х годах Александр Флеминг установил, что плесень, которая случайно попала на поверхность среды с культурой стрептококка, растворила ее. Отсюда Флеминг сделал вывод, что плесень вырабатывает вещество, воздействующее пагубно на бактерии. 12 февраля 1941 года пенициллин впервые применили для лечения человека. Это был лондонский полицейский, страдавший заражением крови. После нескольких инъекций ему стало лучше, и уже через сутки он самостоятельно ел. Но запасы пенициллина быстро закончились, и он умер.
У пенициллина столько преимуществ, что он широко используется в медицинской практике и по сей день. Главная из них - высокая антибактериальная активность. В самом начале он производил впечатление волшебной палочки: очищались гнойные раны, зарастали кожей ожоги, и отступала гангрена. Во время Второй Мировой Войны им активно лечили раненых солдат. Введение пенициллина сразу после ранения позволяло предупреждать нагноение ран и заражение крови.
После того, как появилась возможность получения антибиотиков из микроорганизмов, было открыто многих других видов антибиотиков. В 1939 году был открыт грамицидин, в 1942 - стрептомицин, в 1945 - хлортетрациклин, в 1947 - левомицетин (хлорамфеникол), а уже к 1950 году было выделено более 100 антибиотиков. В настоящее время число используемых антибиотиков достигло десятков тысяч. Много антибиотиков получены из микроорганизмов, населяющих почву. В земле обитают смертельные враги многих опасных для человека микроорганизмов, таких как возбудителей тифа, холеры, дизентерии, туберкулеза и других.
Механизм действия большинства антибиотиков заключается в нарушении проницаемости клеточной мембраны и угнетении синтеза веществ, образующих клеточные мембраны бактерии или белка внутри микробной клетки (в том числе и путем угнетения синтеза РНК). Во всех случаях бактериальная клетка перестает вырабатывать токсины и, следовательно, перестает быть болезнетворной.
Также как и все живые существа, бактерии довольно быстро приспосабливаются к неблагоприятным условиям внешней среды. Они вырабатывают устойчивость к антибиотикам, и через какое-то время любой вид бактерий перестанет быть чувствительной к любому антибиотику. По этой причине людям необходимо изобретать новые препараты.
Ультрафиолетовое облучение
Смертельное воздействие ультрафиолетовых лучей на бактерии изучалось много лет. Ультрафиолетовые лучи имеют низкую проникающую способность и справляются с микроорганизмами, присутствующими на поверхности или рядом с поверхностью облучаемого предмета.
Ультрафиолетовые лучи проникают в ДНК и РНК бактерий, в результате чего их генетический материал повреждается. Чем дольше воздействие ультрафиолета на клетку, тем больше поврежденных частиц. Размножение микроорганизмов прекращается, затем они начинают вымирать.
Стерилизация и дезинфекция
Стерилизацию и дезинфекцию производят для уничтожения вредных бактерий и других микроорганизмов. Для этого применяют химические растворы дезинфицирующих и антисептических средств. Эти средства пагубно действуют на микроорганизмы, подавляя и уничтожая их, и обеззараживают поверхности. По химическому строению различают следующие виды антисептиков: группа галоидов, окислители, кислоты, щелочи, альдегиды, спирты, соли тяжелых металлов, фенолы, красители, мыла, дегти, смолы, продукты переработки нефти, фитонцидные и другие растительные антибактериальные препараты.
Глава 2. Исследовательская работа по уничтожению бактерий
2.1 Выращивание колоний бактерий
Изучив различные методы борьбы с бактериями, я решил проверить, насколько они эффективны. Для этого необходимо вырастить бактерии в домашних условиях.
Для того чтобы создать питательную среду для размножения бактерий, я взял кастрюлю, поставил ее на плиту, налил стакан воды и довел до кипения. Добавил в воду бульонный кубик и пачку желатина. Прокипятил эту смесь в течение 30 минут. Снял кастрюльку с огня и дал ей немного остыть. Затем разлил полученную смесь в емкости, предварительно стерилизованные, и оставил остывать на несколько часов. Когда смесь застыла, я потрогал емкости разными пальцами своей руки. Все емкости я плотно закрыл крышками и положил каждую емкость в пакет, чтобы исключить попадание бактерий из воздуха. Оставил их при комнатной температуре на несколько дней.

День 1. Заселение бактериями
Через 3 дня в емкостях появились мелкие белые и черные точки. Через 5 дней появились первые колонии бактерий, покрытые плесенью.

День 3. Появление бактерий
Через 8 дней колонии бактерий во всех емкостях значительно увеличились, их обильно покрывала плесень, и шел неприятный запах.

День 8. Рост бактерий
Как видно на фотографиях, во всех емкостях присутствуют колонии бактерий, они разного размера и цвета. Это означает, что на наших руках обитает большое количество разнообразных бактерий. Также помимо бактерий на наших руках присутствуют и споры плесневых грибов, которые также являются опасными для здоровья человека.
2.2 Опыт с антибактериальным средством
Проверим, какие средства борьбы с бактериями справятся с выращенными колониями. Сначала я решил проверить, что будет, если капнуть в одну из емкостей обычное антибактериальное средство для рук, купленное в аптеке. Я нанес несколько капель на пятно с бактериями и через 3 дня посмотрел, что же произошло.
Д ень 11. Как видно на фото, антибактериальное средство уничтожило плесень, покрывающую сверху колонию бактерий, и образовало островок, на котором бактерии не размножаются, т.е. колонии бактерий в этом месте не растут, а огибают это место. К сожалению, узнать точно погибли ли бактерии, находящиеся под слоем плесени, не удалось, но в этом месте через несколько дней сама питательная среда стала тоньше, и появилась жидкость на поверхности. Можно лишь сделать предположение, что в этом месте бактерии погибли, тем самым высвободив лишнюю жидкость. Это опыт показывает, что антибактериальное средство из аптеки является эффективным методом в борьбе с бактериями и их распространением.
ень 11. Как видно на фото, антибактериальное средство уничтожило плесень, покрывающую сверху колонию бактерий, и образовало островок, на котором бактерии не размножаются, т.е. колонии бактерий в этом месте не растут, а огибают это место. К сожалению, узнать точно погибли ли бактерии, находящиеся под слоем плесени, не удалось, но в этом месте через несколько дней сама питательная среда стала тоньше, и появилась жидкость на поверхности. Можно лишь сделать предположение, что в этом месте бактерии погибли, тем самым высвободив лишнюю жидкость. Это опыт показывает, что антибактериальное средство из аптеки является эффективным методом в борьбе с бактериями и их распространением.
2.3 Опыт с ультрафиолетовой лампой
Теперь проверим, насколько эффективным является облучение ультрафиолетовой лампой, убивает ли она бактерии. Я поместил под лампу эту же емкость с бактериями на 10 минут и оставил на 2 дня.
День 11. Облучение ультрафиолетовой лампой
Через 2 дня я проверил, что изменилось. В ней произошли огромные изменения, питательная среда стала совсем жидкой, и сами колонии бактерий в ней плавали. Провести какие-либо наблюдения и сравнения было сложно. Можно лишь предположить, что бактерии погибли, в результате чего высвободилась жидкость.
Ультрафиолетовая лампа отлично справилась с бактериями, ее можно рекомендовать как очень эффективное средство для борьбы с бактериями и обеззараживанием помещений.
2.4 Опыты с антибиотиками
В настоящее время самым распространенным методом борьбы с инфекциями является применение различных антибиотиков. Я решил проверить, насколько они эффективны. Я купил в аптеке 2 самых популярных антибиотика Амоксициллин (название лекарства Амосин) и Гентамицин.

Д ля проведения эксперимента с антибиотиками необходимо знать количественное содержание антибиотика в одной таблетке. Затем нужно провести расчеты, чтобы сделать растворы разной концентрации. Так я узнаю, при какой концентрации антибиотика бактерии начинают гибнуть. Антибиотики начинают действовать в крови человека при 1,5–3 мкг/мл, я буду исходить из этих данных. В лекарстве Амосин содержится 500 мг Амоксициллина в 1 таблетке. Мне надо приготовить растворы с концентрацией в 30, 60 и 100 % содержания антибиотика, для этого я использовал метод разбавления. Исходный раствор я получил, растворив 1 таблетку в 100 мл воды, его концентрация составила 500мг/100мл = 5мг/мл. С помощью шприца я взял 1 мл этого раствора и получил растворы нужной мне концентрации. Раствор 1: 50мкг/29мл=1.6 мкг/мл (раствор 30%) Раствор 2: 50мкг/14мл=3.3 мкг/мл (раствор 60%) Раствор 3: 50мкг/9 мл=3.3мкг/мл (самый сильный раствор 100%).
ля проведения эксперимента с антибиотиками необходимо знать количественное содержание антибиотика в одной таблетке. Затем нужно провести расчеты, чтобы сделать растворы разной концентрации. Так я узнаю, при какой концентрации антибиотика бактерии начинают гибнуть. Антибиотики начинают действовать в крови человека при 1,5–3 мкг/мл, я буду исходить из этих данных. В лекарстве Амосин содержится 500 мг Амоксициллина в 1 таблетке. Мне надо приготовить растворы с концентрацией в 30, 60 и 100 % содержания антибиотика, для этого я использовал метод разбавления. Исходный раствор я получил, растворив 1 таблетку в 100 мл воды, его концентрация составила 500мг/100мл = 5мг/мл. С помощью шприца я взял 1 мл этого раствора и получил растворы нужной мне концентрации. Раствор 1: 50мкг/29мл=1.6 мкг/мл (раствор 30%) Раствор 2: 50мкг/14мл=3.3 мкг/мл (раствор 60%) Раствор 3: 50мкг/9 мл=3.3мкг/мл (самый сильный раствор 100%).

День 8. Теперь, чтобы провести эксперимент, я взял для каждого раствора отдельную стерильную пипетку и капнул растворы на поверхность выросшей колонии, а также на пока не зараженные бактериями места. Как видно на фото, 30%-й раствор я капнул сверху, 60%-й – слева, а 100%-й - справа.
День 9. На следующий день колония бактерий увеличилась в размере, на фото можно заметить, что в том месте, где использован 100%-й раствор, колония прекратила рост и стала огибать то место, где нанесен раствор.
День 10. Через 2 дня после обработки антибиотиком отчетливо видно, что место, где нанесен 100%-й раствор, колония бактерий обогнула и продолжила рост. В тех местах, где использовались 30%-й и 60%-й, колония продолжила рост без каких-либо изменений. Также в тех местах, где были нанесены растворы разных концентраций на поверхность колонии, видно, что колония окрасилась в желтый цвет и скукожилась. Возможно, бактерии погибли, осталась только плесень.
День 12. Через 4 дня колония бактерий все же заселила место, обработанное 100%-м раствором Амоксициллина, на фото виден тонкий слой колонии и плесени.
На практике, при лечении, врач всегда назначает курс приема антибиотиков 5-7 дней. В моем опыте я воздействовал антибиотиком однократно, в результате чего бактерии справились с ним и продолжили рост. Этот опыт показывает, что Амоксициллин способен справиться с бактериями, но при условии приема целого курса препарата до полного уничтожения бактерий.
Гентамицин является давно известным антибиотиком, проверим на опыте, какое влияние он окажет на колонию бактерий.

День 9. Я открыл ампулу с Гентамицином и нанес его на поверхность колонии бактерий и рядом, где бактерии пока не размножились.
Д ень 12. Через 3 дня после использования Гентамицина, как видно на фото, колония абсолютно не изменилась в размере, только лишь поменяла свой цвет, стала бледной. Она полностью прекратила развитие.
ень 12. Через 3 дня после использования Гентамицина, как видно на фото, колония абсолютно не изменилась в размере, только лишь поменяла свой цвет, стала бледной. Она полностью прекратила развитие.
Этот опыт показал, что Гентамицин моментально справился с бактериями и предотвратил их распространение. Он является эффективным средством для борьбы с бактериями.
Заключение
Нет такого места на земле, где бы не было бактерий. Человек с ними сталкивается ежедневно, в общественном транспорте, в школе, в магазине, дома. И только от нас зависит, насколько эффективно мы уживаемся с этими крошечными живыми организмами. Существует множество методов борьбы с бактериями, какие-то из них более эффективны, другие менее эффективны. В ходе исследований я убедился, что окружающие нас предметы содержат различные бактерии. Я провел опыты, чтобы проверить насколько эффективны современные методы борьбы с бактериями. Антибактериальные средства и ультрафиолетовая лампа прекрасно справляются с уничтожением бактерий и даже плесени. Антибиотики также показали хорошие результаты. Гентамицин довольно быстро остановил рост бактерий и уничтожил всю колонию. У Амоксициллина результат немного хуже, с распространием бактерий справился только 100%-й раствор антибиотика, менее концентрированные растворы не смогли сдержать их рост, но зато все 3 раствора смогли уничтожить уже имеющиеся бактерии. При этом стоит отметить, что для наилучшего результата Амоксициллин необходимо использовать несколько дней подряд, чтобы полностью уничтожить все бактерии.
Таким образом, мои исследования показали, что существуют отличные методы борьбы с бактериями, которыми можно пользоваться и быть уверенными в их эффективности.
Список использованной литературы
biology.su/bacteria
kipmu.ru/pochemu-ultrafiolet-ubivaet-mikrobov
lektsii.com/1-40773.html
medportal.ru/enc/infection/antibiotic/antibiotic/
mikroby-parazity.ru
moluch.ru/conf/med/archive/253/14195/
pharmprice.kz/article/antiseptiki/
studfile.net/preview/4665829/
www.greatlove.ru/enc/card/1806
www.rlsnet.ru/books_book_id_3_page_117.htm
www.school-science.ru
www.spec-kniga.ru/tehnohimicheski-kontrol/vvedenie-v-mikrobiologiyu-konservirovannyh-produktov/vvedenie-v-mikrobiologiyu-konservirovannyh-produktov-metody-borby-s-mikroorganizmami-vozbuditelyami-porchi-pishchevyh-produktov.html
www.sterilizatori-bmt.ru/sterilizaciya-i-dizinfekciya
Детская Энциклопедия. Микромир, изд-во Росмэн, 2016 г

 Получите свидетельство
Получите свидетельство Вход
Вход











 Современные методы борьбы с бактериями (1.87 MB)
Современные методы борьбы с бактериями (1.87 MB)
 0
0 400
400 1
1 Нравится
0
Нравится
0




